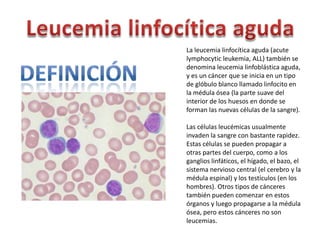
La leucemia linfocítica aguda (acute
lymphocytic leukemia, ALL) también se
denomina leucemia linfoblástica aguda,
y es un cáncer que se inicia en un tipo
de glóbulo blanco llamado linfocito en
la médula ósea (la parte suave del
interior de los huesos en donde se
forman las nuevas células de la sangre).
Las células leucémicas usualmente
invaden la sangre con bastante rapidez.
Estas células se pueden propagar a
otras partes del cuerpo, como a los
ganglios linfáticos, el hígado, el bazo, el
sistema nervioso central (el cerebro y la
médula espinal) y los testículos (en los
hombres). Otros tipos de cánceres
también pueden comenzar en estos
órganos y luego propagarse a la médula
ósea, pero estos cánceres no son
leucemias.

La paciente presenta síntomas de astenia, disnea y fiebre. La exploración revela petequias y parálisis facial central. El análisis de sangre muestra un 95% de blastos mieloides. El mielograma confirma una infiltración del 90% por blastos mieloperoxidasa positivos, diagnosticándose leucemia aguda mieloide sin maduración. A pesar del tratamiento quimioterápico y antibiótico, la paciente sufre una hemorragia cerebral fatal.